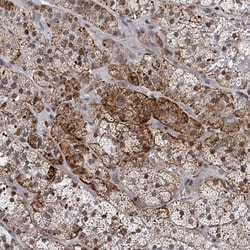
Invitrogen FNDC4 Polyclonal Antibody 100 &mu;L; Unconjugated:Antibodies,

missing translation for 'onlineSavingsMsg'
Learn More
Learn More
Invitrogen™ FNDC4 Polyclonal Antibody


Rabbit Polyclonal Antibody
Brand: Invitrogen™ PA562486
This item is not returnable.
View return policy
Description
Immunogen sequence: IKDNDSNNNP KEKGKGPEQS PQGRPVGTRQ KKSPSINTID V Highest antigen sequence identity to the following orthologs: Mouse - 98%, Rat - 100%.
Acts as an anti-inflammatory factor in the intestine and colon. Binds to and acts on macrophages to downregulate pro-inflammatory gene expression. Affects key macrophage functions, including phagocytosis, by downregulating many key pathways for macrophage activation, partly via by STAT3 activation and signaling. May be required to dampen the immunological response in colitis.
Specifications
| FNDC4 | |
| Polyclonal | |
| Unconjugated | |
| FNDC4 | |
| 2810430J06Rik; 6330410H20Rik; AB030187; AI838506; AW487863; fibronectin type III domain containing 4; fibronectin type III domain-containing protein 4; fibronectin type III repeat containing protein 1; fibronectin type III repeat-containing protein 1; Fndc4; Fnmp1; FRCP1; UNQ6389/PRO21134 | |
| Rabbit | |
| Antigen affinity chromatography | |
| RUO | |
| 64838 | |
| Store at 4°C short term. For long term storage, store at -20°C, avoiding freeze/thaw cycles. | |
| Liquid |
| Immunohistochemistry (Paraffin) | |
| 0.05 mg/mL | |
| PBS with 40% glycerol and 0.02% sodium azide; pH 7.2 | |
| Q9H6D8 | |
| FNDC4 | |
| Recombinant protein corresponding to Human FNDC4. Recombinant protein control fragment (Product #RP-101209). | |
| 100 μL | |
| Primary | |
| Human | |
| Antibody | |
| IgG |
Product Content Correction
Your input is important to us. Please complete this form to provide feedback related to the content on this product.
Product Title
Spot an opportunity for improvement?Share a Content Correction